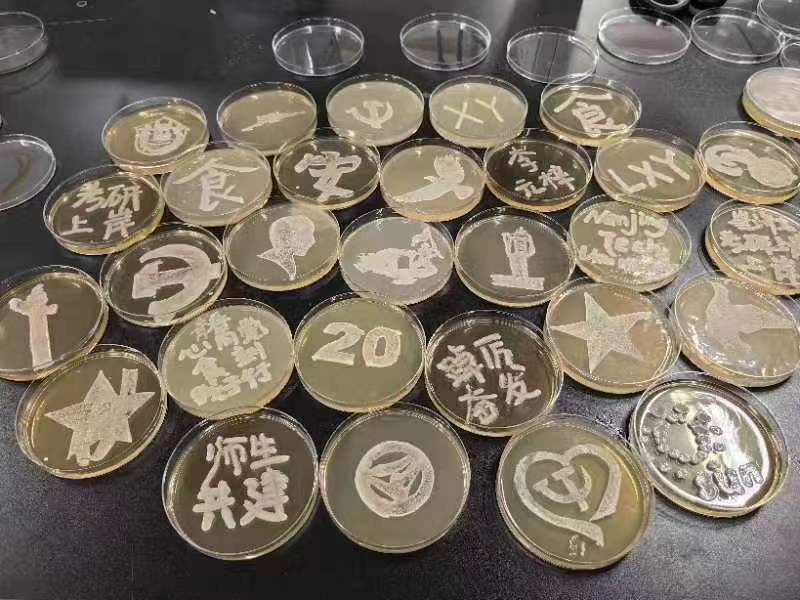

- 阅读次数:
- 发布时间:2022-12-12
为学习宣传贯彻党的二十大精神,提高员工科研实践创新能力,加强师生交流,实现党建、思政与专业教育一体化深度融合,12月1日-3日,公司开展“青春心向党,食刻践于行”师生共建主题教育实践,太阳成城集团tyc234cc古天乐党委书记张琪、教师第一党支部教师、实验教学中心主任刘洋、食品质量与安全专业党支部成员与各年级积极分子参加,座谈会由公司团委副书记李元梓主持。
会上,教师第一党支部书记徐铮带领全体师生集中学习了党的二十大报告,特别是关于教育、科技、人才的重要论述,强调坚持教育优先发展,坚持创新驱动,坚持人才是第一资源。师生们围绕专业学习、科研实践、职业规划和老员工活等展开交流,倾情分享,温度对话。张书记充分肯定了此次实践的教育意义,鼓励党支部突出价值引领作用,教师发挥经验优势,同学们积极探索与创新实践。
拓宽专业学习认知,刘洋老师带来了一场生动形象的微生物小课堂,讲授了实验室无菌操作以及不同微生物的生长特性、在不同培养基上的颜色表现、生长速度、菌落性状等,结合前期的作品设计,探讨可行的“绘制”方法。
同学们身穿实验服,走进实验室,在老师们的指导下,以微生物平板为画布,以酵母菌为颜料,进行“青春心向党”主题创作,“刻画”出自己心中的浓浓爱国情,化无形为有形。24小时后,一幅幅描述党史故事,展现公司、公司和专业发展内涵的作品跃然“菌”上,大家互相展示自己的成果,分享创作的喜悦并拍照留念。
此次实践以“党建+”引领专业建设,强化思想引领,凝聚精神力量,生动展现出公司青年基于专业学习和科研探索而诠释的爱党爱国情怀,立志坚定不移把党的二十大精神融于心、铸于魂、践于行。
作者:卢冰倩 李元梓 摄影:蔡兴茹 审核:王浩
